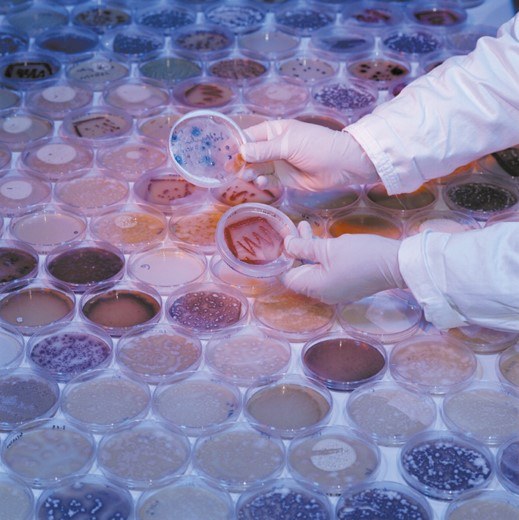

Qu'est ce que l'école doctorale en sciences vétérinaires (EDV) ?
Destinée aux doctorants et aux promoteurs des thèses en sciences vétérinaires, l'EDV poursuit deux missions: favoriser les échanges d'expertise et assurer la promotion des événements liés à la formation des chercheurs en sciences vétérinaires. Quatre universités sont associées dans le cadre de l'EDV (UCL, ULB, ULg et UNamur). Cette école profite du partenariat avec trois instituts (ARSIA, Sciensano, CER), tous actifs dans le domaine de la recherche vétérinaire.
Pour répondre aux deux missions de l'EDV, ce site héberge la plate-forme de cours de spécialisation disponibles dans les quatre universités.
Le site de l'EDV est également un outil d'information et de promotion utilisé pour
- mettre en avant des recherches originales réalisées par des équipes partenaires du réseau
- communiquer l'agenda des conférences données par des orateurs de renommée internationale
- assurer l'organisation de la journée des doctorants (PhD student day) du réseau de l'EDV
Ce site est un lieu d'échange pour tous les chercheurs au service de la recherche vétérinaire.